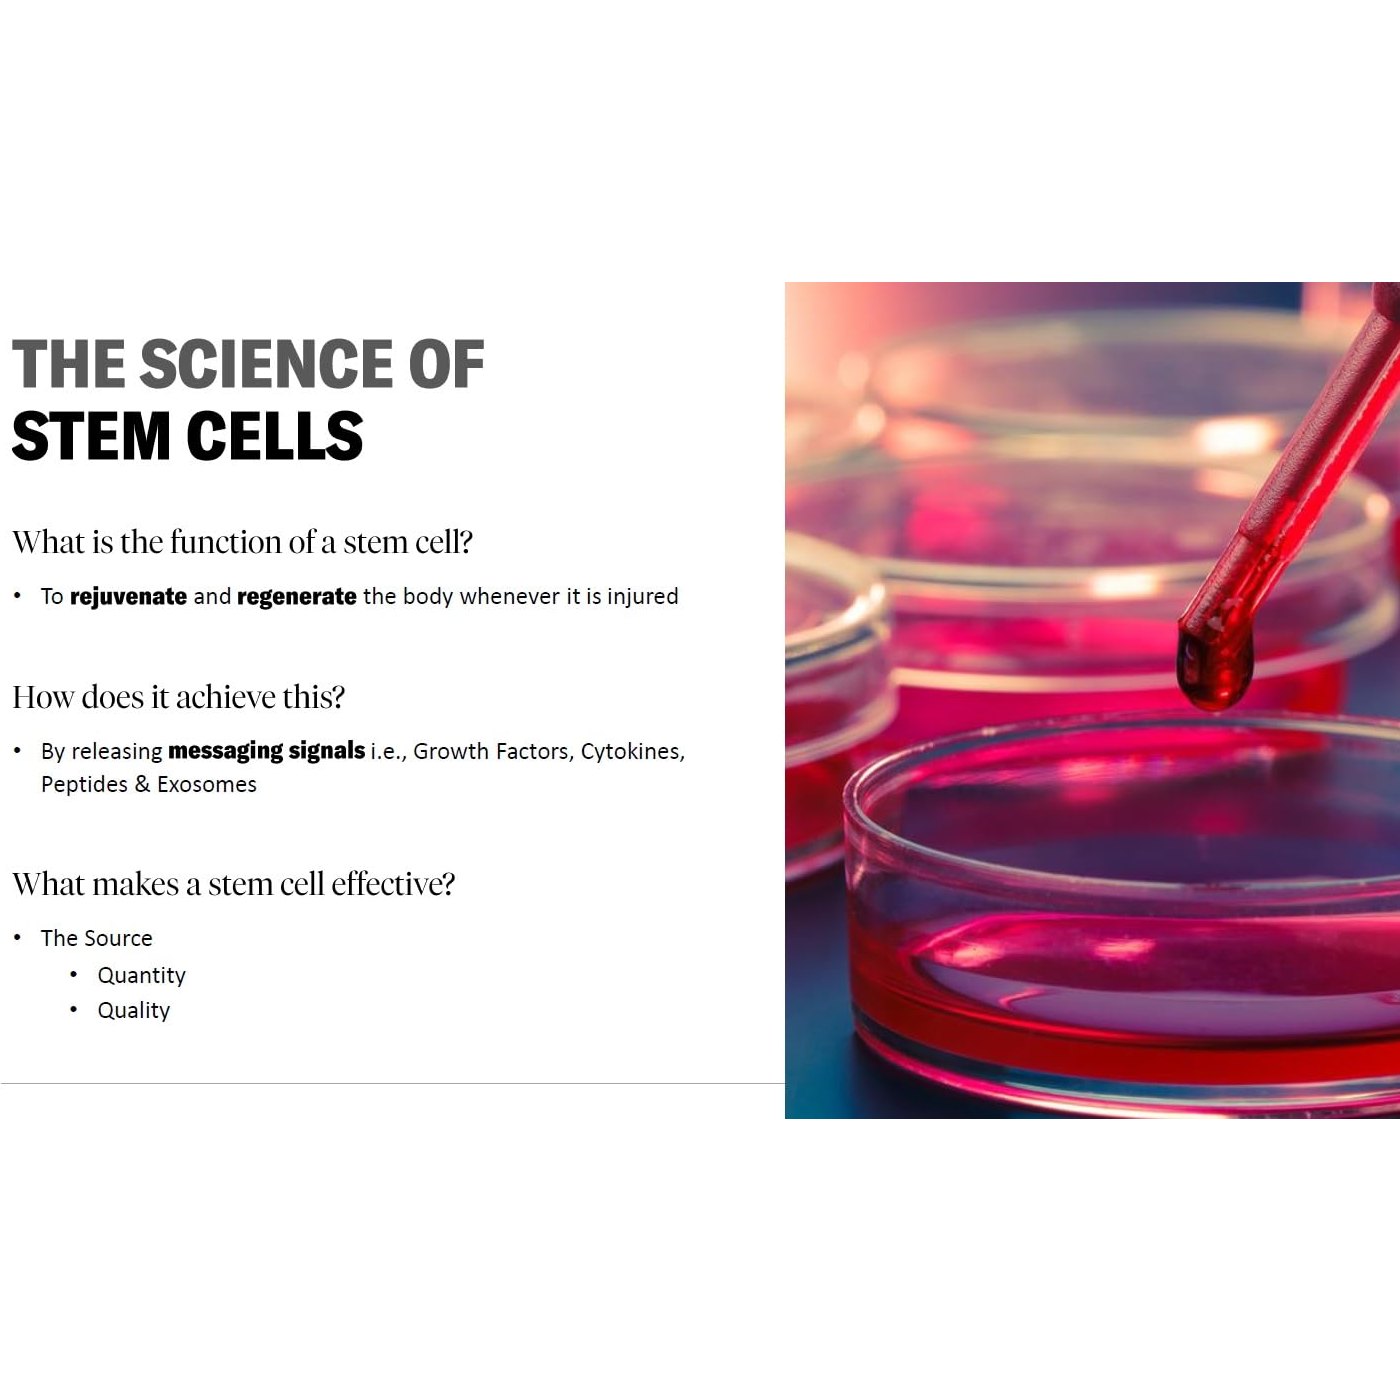
Calecim Professional Serum 5 ml (6) - Medaid International

Calecim Professional Serum 5 ml (6)
Calecim Professional Serum 5 ml (6)
Regular price
$0.00 USD
Regular price
Sale price
$0.00 USD
Unit price
per
Shipping calculated at checkout.
Couldn't load pickup availability
Brand: Calecim Professional
Features:
- Stem Cell Growth Factors
- Skin type: All
- Target use body part: face
- Product benefit: Regenerate, rejuvenate, revitalize, repair, age defy, wrinkles, acne scars, sun damages
- Scent: Aloe vera
EAN: 8881300236045
Package Dimensions: 7.1 x 4.7 x 2.0 inches
Shipping & Returns
Shipping & Returns
Due of the nature of this product and for sanitary reasons, exchanges and returns are not permitted.







-
Shipping
Shipping Charges:
- Lebanon: Free shipping for most areas in Beirut for orders above $50, otherwise $2.99 shipping fee within Beirut. $3.99 shipping fee to the rest of Lebanon.
- Rest of the world: Custom shipping charge for the rest of the world.
Shipping Time:
- Lebanon: Look for items with the “READY SHIPPING” badge for immediate delivery within Beirut, otherwise shipping takes 2 to 10 days.
- Rest of the world: Shipping typically takes 5 to 30 business days, depending on the location.
-
No Exchanges Permitted
Due of the nature of this product and for sanitary reasons, exchanges and returns are not permitted.